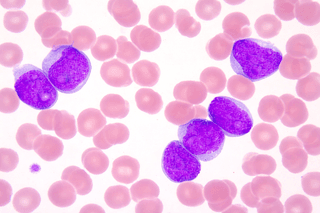
Leukocyter – En översikt av de olika typerna och deras betydelse

Säkerställ din hälsostatus och få insyn om ditt immunförsvar med B-celltest och differentialräkning av leukocyter.
Detta hälsotest ger en detaljerad analys av dina vita blodkroppar, vilket är avgörande för att övervaka ditt immunförsvar och identifiera eventuella avvikelser som kan indikera underliggande hälsoproblem.
Vilka analyser ingår vid B-celler och differentialräkning av leukocyter?
B-celler testet innefattar differentialräkning av följande leukocyttyper, se även referens intervall:
- B-Leukocyter: Normala värden ligger mellan 3,5 - 8,8 x 10<sup>9</sup>/L. Dessa celler spelar en central roll i kroppens immunförsvar.
- B-Neutrofila granulocyter: Med referensvärden på 1,6 - 5,9 x 10<sup>9</sup>/L, är dessa vitala för att bekämpa infektioner.
- B-Lymfocyter: Normala intervall på 1,1 - 3,5 x 10<sup>9</sup>/L. Lymfocyter är avgörande för kroppens adaptiva immunrespons.
- B-Monocyter: Dessa celler, som varierar mellan 0,2 - 0,8 x 10<sup>9</sup>/L, är viktiga för att avlägsna döda eller skadade celler och bekämpa vissa typer av infektioner.
- B-Eosinofila granulocyter: Med ett referensvärde på mindre än 0,5 x 10<sup>9</sup>/L, är dessa inblandade i kroppens respons mot allergier och parasitinfektioner.
- B-Basofila granulocyter: Dessa är minst vanliga med normalvärden under 0,1 x 10<sup>9</sup>/L och spelar en roll i allergiska reaktioner.
Vad används B-celltestet för?
Genom att analysera dessa olika typer av vita blodkroppar kan vårt test ge värdefull information om ditt nuvarande hälsotillstånd och bidra till tidig upptäckt av möjliga immunrelaterade tillstånd. Ett venöst blodprov är ett säkert, snabbt och effektivt sätt att få en ögonblicksbild av hur väl ditt immunsystem fungerar. Ett antal vita blodkroppar används oftast för att hjälpa till att diagnostisera störningar relaterade till att ha ett högt antal vita blodkroppar eller lågt antal vita blodkroppar.
Höga avvikande värden av vita blodkroppar kan inkluderar:
- Autoimmuna och inflammatoriska sjukdomar, tillstånd som gör att immunsystemet attackerar friska vävnader
- Bakteriella eller virusinfektioner
- Cancer som leukemi och Hodgkins sjukdom
- Allergiska reaktioner
Låga avvikande värden av vita blodkroppar kan relateras till:
- Sjukdomar i immunsystemet, såsom HIV/AIDS
- Lymfom, en cancer i benmärgen
- Sjukdomar i levern eller mjälten
B-cellertestet rekommenderas för:
- Individer som önskar en omfattande utvärdering av sitt immunförsvars status.
- Personer med symtom på infektion eller inflammation som önskar en klarare diagnos.
- De som följer upp befintliga hälsotillstånd eller behandlar specifika sjukdomar relaterade till immunsystemet.
- Hälsomedvetna individer som vill ha regelbundna uppdateringar om sin hälsa.